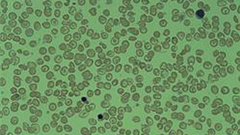
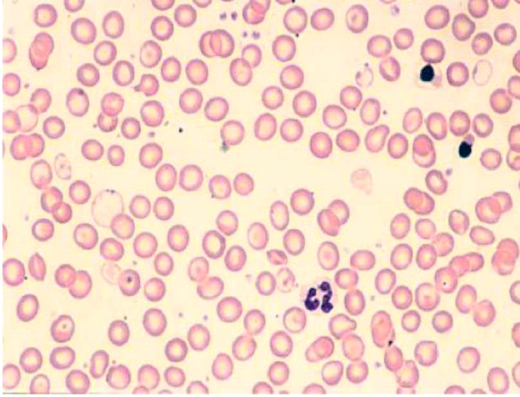

תלסמיה - טיפול ומניעה - Thalassemia - treatment and prevention
| תלסמיה - מניעה וטיפול | ||
|---|---|---|
| Thalassemia - prevention and treatment | ||
| ||
Peripheral blood film from a person with Delta Beta thalassemia
| ||
| שמות נוספים | תלסמיה או אנמיה ים תיכונית - אבחנה, טיפול ומניעה | |
| ICD-10 | Chapter D 56. | |
| ICD-9 | 282.4 | |
| MeSH | D013789 | |
| יוצר הערך | פרופ' אריאל קורן | |
לערכים נוספים הקשורים לנושא זה, ראו את דף הפירושים – המוגלובינופתיות
תלסמיה היא מחלת דם תורשתית, אשר מתפתחת כתוצאה מפגם במרכיב החלבוני של ה-Hemoglobin (Hb). עד תחילת שנות האלפיים, נאלצו החולים הסובלים מתלסמיה ו-Hemosiderosis לקבל טיפול על ידי הזלפה תת-עורית בעזרת משאבה, במשך כמחצית משעות היממה. בשנות השמונים של המאה ה-20 נכנס לשימוש תכשיר הניתן דרך הפה (Per os) לטיפול ב-Hemosiderosis ובשנת 2005 אושר תכשיר נוסף.
מחלת התלסמיה שייכת לקבוצת האנמיות ההמוליטיות התורשתיות (Hereditary hemolytic anemias), הקשורות לפגם במבנה ה-Globin (Hemoglobinopathies), שהוא המרכיב החלבוני של ה-Hemoglobin.
את ה-Hemoglobinopathies ניתן לחלק לפגמים הקשורים למבנה ה-Globin, לדוגמה אנמיה חרמשית (Sickle-cell anemia) ולמחלות הקשורות לכמות הייצור של חלבון זה, אלו הן התלסמיות.
מבנה ה-Globin מורכב משני זוגות של שרשראות, כאשר באדם בוגר בריא, רוב ה-Globin מורכב מ-Hemoglobin מסוג A, המורכב משתי שרשראות מסוג α (Alpha) ושתי שרשראות מסוג β (Beta), כלומר, ההרכב הוא α2β2 (Alpha 2 beta 2). ה-Hemoglobin העוברי (Fetal hemoglobin, HbF), שהרכבו הוא α2γ2 (Alpha 2 gamma 2), מהווה חלק קטן מכלל ה-Hemoglobin. סוג נוסף של Hemoglobin, המהווה פחות מ-3.5 אחוזים, הוא ה-Hemoglobin A2 שהרכבו הוא α2δ2 (Alpha 2 delta 2). השמות של מחלות התלסמיה ניתנים על פי סוג השרשראות החסרות: α תלסמיה או β תלסמיה.
התורשה של מחלות אלו מועברת בצורה אוטוזומלית רצסיבית (Autosomal recessive).
מחלת התלסמיה נחשבת לפגם הגנטי (Genetic) הנפוץ ביותר בעולם - מעל 100 מליון נשאים וכ-120,000 לידות של חולים חדשים הנוספים מדי שנה. אזורים אנדמים למלריה (Malaria endemic areas) הם האזורים בהם שכיחות ה-Hemoglobinopathies גבוהה במיוחד, עקב עמידות הנשאים לזיהום על ידי טפיל זה. האזור המכונה "חגורת התלסמיה" (Thalassemia belt) הוא האזור המשתרע מספרד בקצה המערבי של אגן הים התיכון, ועד לדרום מזרח אסיה. באגן הים התיכון נפוצה בעיקר β תלסמיה, וה-Hemoglobinopathies השכיחות בדרום מזרח אסיה הן α תלסמיה ו-thalassemia Hemoglobin E. בישראל, תלסמיה נפוצה באוכלוסיות שונות מבחינת המוצא האתני, כאשר באוכלוסייה היהודית כ-20 אחוז מיוצאי כורדיסטן נושאים גן זה ובאוכלוסייה הערבית השכיחות נעה בין 5 ל-10 אחוזים באזורים שונים. בישראל ידועים כ-600 חולים הלוקים ב-Hemoglobinopathies שונות, רובם חולי β תלסמיה. גם הגן ל-α תלסמיה נפוץ בישראל. גן זה קיים הן באוכלוסייה המזרח תימנית, יהודית וערבית, ואף ביהודים ממוצא אשכנזי.
α תלסמיה
בכל אחד מן הכרומוזומים (Chromosomes) בזוג הכרומוזומים מספר 16, קיימים שני גנים (Genes) המקדדים (Codes) את יצור שרשראות ה-α-globin. מצב של חסר או מוטציה (Mutation) באחד או בשני גנים, גורם למצב קליני של נשאות. חסר או מוטציה בשלושה גנים גורם למחלה המוליטית קלה עד בינונית, המכונה disease Hemoglobin H (HbH). חסר או מוטציה בארבעת הגנים גורם למצב המכונה Hydrops fetalis, והוא אינו מאפשר חיים. מצב זה איננו נפוץ באגן הים התיכון ולעומת זאת נפוץ בדרום מזרח אסיה.
β תלסמיה
הגן המקדד את יצור חלבון ה-β-globin נמצא בכרומוזום 11, בסמוך לגנים המקדדים את יצור שרשראות ה-γ-globin וה-δ-globin. במקרה של β תלסמיה, החסר של שרשראות β-globin יכול להיות חלקי, מצב המכונה +β תלסמיה, או חסר מלא המכונה β0 תלסמיה. קיימות 3 צורות קליניות של β תלסמיה הנעות מדרגת חומרה קלה לקשה:
- תלסמיה קטנה (Thalassemia minor) - נשאים בעלי מוטציה באחד מתוך שני הגנים, בעלי הסתמנות קלינית קלה
- תלסמיה בינונית (Thalassemia intermedia) - חולים בדרגת חומרה משתנה, לרוב הומוזיגוטיים למוטציות אופייניות מסויימות
- תלסמיה גדולה (Thalassemia major) - חולים הומוזיגוטיים (Homozygous), הם החולים הקשים
הפתופיזיולוגיה (Pathophysiology) של β תלסמיה קשורה בעיקר לעודף היחסי של שרשראות α-globin אשר לא מייצרות את ה-Hemoglobin הבוגר, עקב מחסור בשרשראות β-globin. עקב זאת, נוצר עודף יחסי של HbF, ושארית שרשראות ה-α-globin עוברות Denaturation ושקיעה בתוך הכדוריות האדומות (Red blood cells) (תמונה 1).
שקיעתן של שרשראות α-globin העודפות גורמת לשינויי צורתן של הכדוריות האדומות, המקבלות כעת את המראה האופייני של תאי מטרה (Target cells) (תמונה 2). לכדוריות אדומות אלו אורך חיים קצר משמעותית ביחס ל-120 הימים של כדורית אדומה רגילה. עקב כך, נגרמות הגברה של התהליך ההמוליטי, הגדלה של הטחול ואנמיה.
מצד שני, ההרס המוגבר של הכדוריות האדומות, הלא תקינות, גורם ל-Erythropoiesis בלתי יעיל בתוך לשד העצמות (Bone marrow), דבר המוביל גם הוא לאנמיה. ל-Hemoglobin העוברי יכולת קשירת חמצן מוגברת אבל קושי במסירת חמצן ברקמות. עקב כך נגרמת Hypoxia ברקמה. כל התהליכים הללו גורמים להגברת ייצור ה-Erythropoietin ולפעילות יתר של Erythropoiesis גם בלשד העצמות וגם במקומות אשר בדרך כלל אינם משתתפים בתהליך זה, מצב המכונה Extramedullary erythropoiesis. מצב זה גורם לעיוותים כגון: לסתות בולטות, מצח בולט, עצמות שבירות ועוד. ה-Erythropoiesis המוגבר מעלה את ספיגת הברזל (Iron) מהמעיים, תהליך אשר בסופו של דבר יגרום ל-Hemosiderosis. תהליך זה מווסת על ידי חלבון ה-Hepcidin, אשר מאפשר ספיגה מוגברת של ברזל למרות מצב עודף הברזל הקיים בחולי תלסמיה. בנוסף, חולי תלסמיה בוגרים סובלים מ-Osteoporosis עקב ה-Erythropoiesis המוגבר, וחלקם סובלים גם מתת פעילות של בלוטת יותרת התריס (Hypoparathyroidism).
הטיפול בחולי תלסמיה
עירויי דם ו-Hemosiderosis
חולי β תלסמיה מפתחים אנמיה משמעותית בסביבות גיל חצי שנה והחל מגיל זה זקוקים לקבלת עירויי דם (Blood transfusions). מטרת מתן עירויי הדם היא לאפשר רמת Hemoglobin סבירה כדי לגדול ולהתפתח, אך לא רק. מתן עירויי דם בתדירות קבועה, לרוב כל 2 עד 4 שבועות, מונעת את העיוותים בשלד, מפחיתה את הגדלת הטחול ומדכאת את ה-Erythropoiesis הבלתי יעיל. המטרה היא לשמור את החולים ברמת Hemoglobin בסיסית שבין 9 ל-10 גרם/ד"ל (דציליטר), כאשר בגילאים הצעירים רצוי לשמור על רמת Hemoglobin גבוהה יותר ולאחר גיל ההתבגרות ניתן להוריד את הסף הבסיסי של ה-Hemoglobin.
Hemosiderosis
כל מנת דם מכילה בין 200 ל-250 מ"ג (מיליגרם) ברזל. כתוצאה ממתן עירויי הדם וה-Hematopoiesis המוגבר, נוצר מצב של עודף ברזל אשר גוף האדם איננו מסוגל להפריש. עודף הברזל שוקע במערכת הרטיקולואנדוטליאלית (Reticuloendothelial) ובכל רקמות הגוף, כולל בעור, וכתוצאה מכך מקבל העור צבע דמוי נחושת האופייני לחולים אלה. הברזל שוקע גם בכבד, בלב ובכל המערכת האנדוקרינית (Endocrine system). כתוצאה מכך, כבר בעשור השני לחייהם, חולי β תלסמיה מפתחים Cardiomyopathy והפרעות קצב, תת פעילות של בלוטת יותרת התריס, ושל בלוטת התריס (Hypothyroidism), איחור בגדילה ובהתבגרות. שקיעת ברזל בלבלב גורמת לסוכרת תלויית אינסולין [(Insulin Dependent Diabetes Mellitus (Type 1]. האיחור בהתבגרות בולט יותר בבנים מאשר בבנות וקשור למצב עודף הברזל הקיים עוד לפני גיל ההתבגרות. קצב הגדילה השנתי של חולי תלסמיה נמוך משמעותית לעומת נערים/ות בריאים/ות.
קיימות מספר שיטות להערכת מידת ה-Hemosiderosis:
- המדד המקובל להערכת חומרת ה-Hemosiderosis הוא בדיקת רמת Ferritin. ה-Ferritin הוא חלבון המשקף את מאגרי הברזל. יחד עם זאת, רמת פריטין מושפעת מגורמים שונים, כגון מחלות חריפות (Acute) וכרוניות (Chronic), ולכן אין להסתמך על בדיקה בודדת, אלא על מגמות השינויים בפרקי זמן ארוכים יחסית
- הנזק של עודף הברזל קשור בעיקר בברזל אשר אינו קשור ל-Transferrin (Non-Transferrin-Bound serum Iron, NTBI), ברזל חופשי זה שוקע ברקמות השונות וגורם לנזקים שתוארו. בדיקת רמות הברזל שאינו קשור ל-Transferrin יכולה להעריך את כמות הברזל החופשי, אבל זו איננה בדיקה שגרתית
- הדרך המקובלת כיום (נכון לשנת 2013) להערכת ה-Hemosiderosis, אם כי מדובר בפעולה פולשנית, היא בדיקת כמות הברזל ברקמת כבד שהתקבלה מביופסית מחט (Needle biopsy). המגבלה של בדיקה זו, בנוסף להיותה פעולה פולשנית, היא שפיזור שקיעת הברזל ברקמת הכבד איננו אחיד ולכן הבדיקה יכלה לדגום אזורים עם כמויות משתנות של ברזל בין אזור לאזור
- שיטה נוספת, אשר הוכנסה לשימוש בתחילת שנות האלפיים, היא הדמייה בעזרת MRI (Magnetic Resonance Imaging) בשיטה המכונה T2, שיטה המסוגלת להעריך את כמות הברזל בכבד, ובשיטת ה-*T2 אשר נועדה להעריך את כמות הברזל בשריר הלב. עם הכנסת שתי שיטות אלו, הוכח שאין התאמה מלאה בין עומס הברזל בלב ועומס הברזל בכבד, וזו מגבלה נוספת של בדיקת כמות הברזל ברקמת כבד מביופסיה. שיטת T2-MRI מסוגלת גם להעריך את שקיעת הברזל בלבלב ובבלוטת יותרת המוח (Pituitary gland)
טיפול תרופתי בעודפי הברזל
את הנזקים של עודף הברזל בחולי תלסמיה ניתן למנוע על ידי טיפול בקושרי ברזל (Iron chelators). הטיפול המקובל מזה יותר מארבעה עשורים הוא על ידי Desferal (Deferoxamine mesylate), תכשיר אשר ניתן בהזלפה תת-עורית בעזרת משאבה, שישה ימים בשבוע במשך כעשר שעות ביממה. לתכשיר זה זמן מחצית חיים קצר של כחצי שעה ולכן יש להזליפו במשך 8 עד 10 שעות ביממה. נוסף לכך, לא ניתן לתת אותו פומית (Per os). ההזלפה במשך 8 עד 10 שעות, משאירה את יתר היממה ללא טיפול, ובזמן זה הברזל החופשי ב-Plasma עולה ושוקע ברקמות. הטיפול ב-Desferal בהזלפה מתמשכת, גורם להיענות נמוכה של החולים לטיפול. יחד עם זאת, חשוב לציין שטיפול סדיר מונע את כל סיבוכי ה-Hemosiderosis ומאפשר חיים רגילים ותוחלת חיים ההולכת וגדלה. במצב של תופעות לבביות, ל-Desferal היכולת להוציא ברזל משריר הלב וממערכת ההולכה ועל ידי כך לשפר את התפקוד הלבבי. במצבים של Hemosiderosis קשה, ניתן להזליף מינונים גדולים יותר של Desferal במשך רוב שעות היממה דרך צנתר מרכזי (Central venous catheter), או בהזלפה תת עורית. טיפול זה מסוגל להציל את חייהם של חולי תלסמיה עם Cardiomyopathy קשה. יחד עם זאת, הנזקים האנדוקריניים (Endocrine) הם ככל הנראה בלתי הפיכים. תופעות הלוואי העיקריות של Desferal הן תגובה מקומית במקום ההזרקה ונזק בשמיעה ובראיה הקשורים ככל הנראה, לטיפול במינון עודף.
תכשיר נוסף המסוגל לגרום להפרשת הברזל העודף הוא ה-Ferriprox (Deferiprone). היתרון הבולט של תכשיר זה טמון באפשרות לתת אותו דרך הפה, ובזמן מחצית החיים שלו (כשתיים עד שלוש שעות) המאפשר מתן של התרופה שלוש פעמים ביום. תופעות הלוואי של תכשיר זה הן נזקים ל-Synovium של המפרקים וירידה במספר הנויטרופילים (Neutropenia), אשר לעיתים הינה בלתי הפיכה. עקב זאת, התכשיר לא הצליח לתפוס את מקומו של Desferal כתכשיר קושר הברזל הנבחר בטיפול בחולי תלסמיה.
חלופה שכן נכנסה לשימוש נרחב, הינה מתן שילוב של Desferal ו-Ferriprox.
הפרוטוקולים (Protocols) הטיפוליים של השילובים הם שונים ונעים בין מתן Desferal שלושה עד ארבעה ימים בשבוע ו-Ferriprox ביתר ימי השבוע, עד לשילוב יומיומי של שני התכשירים. היתרון היחסי של Ferriprox הוא יכולתו לסלק בצורה יעילה יותר את הברזל משריר הלב.
בשנת 2005, אושר, על ידי מנהל המזון והתרופות האמריקאי (Food and Drug Administration, FDA) ומשרד הבריאות בארץ, השימוש בתכשיר חדש: Exjade (Deferasirox). לתכשיר זה, הניתן דרך הפה, זמן מחצית חיים של 12 עד 16 שעות, דבר המאפשר ליטול אותו פעם ביום. תופעות הלוואי קשורות בעיקר לדרכי העיכול (בחילות ושלשולים) ופריחות בעור, הן לרוב חולפות עם המשך הטיפול בתכשיר ואינן מצדיקות הפסקת הטיפול. כמו כן, נצפתה עלייה קלה ברמת ה-Creatinine, אך עלייה זו אינה חורגת מהרמה המירבית התקינה לגיל החולה. התוצאות שהתקבלו בניסוי במאות חולים מראות, שיעילות התכשיר דומה ליעילות של Desferal עם יתרון בדרך מתן התכשיר, דבר אשר מבטיח היענות טובה יותר לטיפול מצד החולים.
- שלושת התכשירים נמצאים בסל הבריאות בארץ לטיפול במצבי עודף ברזל כתוצאה מעירויי דם, על רקע מחלות מולדות/תורשתיות
השתלת מח עצם
האפשרות היחידה להבראת חולי התלסמיה היא השתלת תאי אב של לשד העצם (Hematopoietic stem cell transplantation), פעולה אשר אפשרית רק בחלק מהחולים וזאת בשל הצורך במציאת תורם מתאים מבחינת התאמת רקמות. יש לציין, כי חולים השייכים לקבוצת סיכון נמוכה אשר מאופיינים בהיעדר הגדלת הכבד, טיפול סדיר בקושרי ברזל והעדר Fibrosis בכבד, הם בעלי סיכוי של כ-90 אחוז להבריא לאחר השתלת תאי אב מסוג זה.
שיקולים כללים בטיפול
הטיפול הכוללני בחולי β תלסמיה מצריך שיתוף של צוותים גדולים הכוללים רופאים המטולוגים (Hematologists), אחיות, רופאים קרדיולוגים (Cardiologists), אנדוקרינולוגים (Endocrinologists), אורתופדים (Orthopedists), רופאי פה לסת, עובדים סוציאליים, עובדי מעבדה ובנק הדם, יחידות אשפוז יום ועוד. מכאן, שעלות הטיפול בכל חולה בוגר מגיעה ל-40,000 דולר בשנה, כלומר במשך 50 שנות חיים מדובר בהוצאה של לפחות 2,000,000 דולר לטיפול בחולה בודד. נכון להיום, בעשור השני של שנות האלפיים, תוחלת החיים של חולי תלסמיה המטופלים באופן סדיר עם היענות טובה לטיפול, עוברת את גיל 50, ויש לצפות שחולים הנמצאים בשנות העשרים והשלושים לחייהם, יאריכו ימים עוד יותר. מילת המפתח, ללא ספק, היא היענות טובה וקפדנית בטיפול בקושרי ברזל, בנוסף לעירוי דם.
מניעת המחלה
הואיל ותלסמיה היא מחלה קשה לחולה ויקרה למערכת, יש מקום לפתח תוכניות למניעתה. הפעלת מערכת הסברה אינה מספיקה על מנת להגיע לכלל הזוגות בסיכון ואת תוצאותיה ניתן לראות רק לאחר שנים רבות. הפעלת תוכנית לאיתור זוגות בסיכון להוליד ילדים חולים, נותנת לבני הזוג את האפשרות לבצע אבחון טרום לידתי והפסקת היריון, במידה וזהו רצונם.
ביבליוגרפיה
קישורים חיצוניים
- תלסמיה או אנמיה ים תיכונית - אבחנה, טיפול ומניעה, TheMEDICAL
המידע שבדף זה נכתב על ידי פרופסור אריאל קורן, מנהל מחלקת ילדים ב' והיחידה להמטולוגיה פדיאטרית (Pediatric hematology), מרכז רפואי העמק, עפולה. פרופסור חבר קליני, הפקולטה לרפואה על שם רות וברוך רפפזרט, הטכניון, חיפה
הצהרת גילוי נאות:
פרופסור קורן הועסק כיועץ רפואי כנושא של הערכה וטיפול בעודף ברזל בחולי אנמיה חרמשית, והשתתף במחקר בטיפול בחולי תלסמיה בתכשיר Exjade Deferasirox מטעם חברת Novartis. כמו כן, הוא משמש כיועץ רפואי בנושא Hemoglobinopathies על ידי חברת Apopharma המשווקת את התכשיר Deferiprone בארץ.


 כניסה
כניסה  עקבו אחרינו בפייסבוק
עקבו אחרינו בפייסבוק